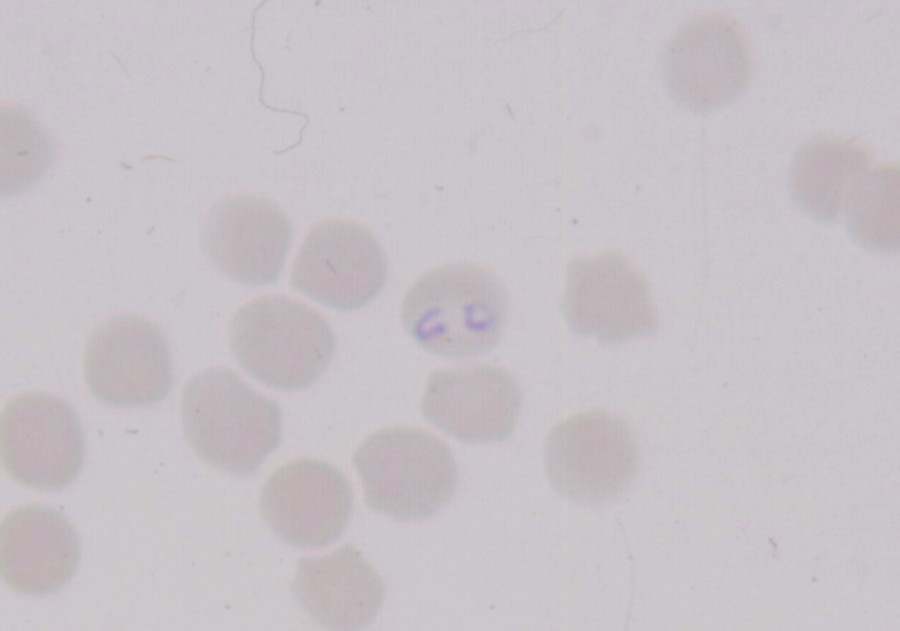

kaskade
Pour le coup, je viendrais contre argumenter ton propos
Parce que tu as exactement la même réaction et la même posture que tous les vétérinaires qui sont passés à côté d'une lyme, ehrlichiose et compagnie
Parfois avec tellement d'obstination et de certitudes car le tableau clinique ne laissait justement rien transparaitre, que certains chevaux sont arrivés à des états lamentables où l'on ne proposait au propriétaire qu'une euthanasie finale. c'est du vécu, hélas.
Il n'y a pas que la piro dans le syndrome pirolike, c'est d'ailleurs souvent les autres maladies qui sortent, pas celle ci.
Je parle d'expérience. Sinon, je ne me permettrais jamais ce contre argumentaire.
Je ne sais pas où en est la progression de ce syndrome en Suisse, mais en France, les cas se multiplient et les diagnostics sont encore rarement posés en premiere intention parce que, c'est toi qui le dit :
Citation :
Pour rappel lors de lexamen clinique dune piroplasmose on remarque :
Un bon abattement, une forte fièvre (autour des 39°), respiration forcée, naseaux dilatés, pouls élevé. Laspect des conjonctives nous frappe par son teint blanc porcelaine ou orangée. Il ne mange plus ou boude
A la première description on na rien de tout ça ! Alors ça peut être nimporte quel virus qui rode dans le coin
et auquel on ne mettra jamais un nom
les véto focalisent encore systématiquement sur une belle description de la piro dans toute sa splendeur et uniquement de celle-ci sans envisager ses copines vicieuses qui se cachent sous des tableaux cliniques aléatoires et des faux négatifs. Et pourtant
.
Je répète, le syndrome pirolike porte aussi le surnom inspirant de "fière isolée"... C'est peut-être le symptôme le plus commun entre elles mais parfois, même pas !
Certes une fièvre isolée c'est potentiellement tout et n'importe quoi. mais en France, où la panoplie des maladies transmises par les tiques progressent, si on a la possibilité de les écarter au plus tôt d'un diagnostic pour quelques dizaines d'euros, vu la tournure des choses en cas de diags tardifs
. ce serait dommage de s'en priver. Ce sont des maladies auto-immunes qui ouvrent la porte à toutes les pathologies possibles.
Avec tout le respect que je te dois .
Je n'insisterais jamais assez auprès de chaque personne postant sur CA la description d'un cheval ayant un ou plusieurs signes associés au syndrome sur l'utilité d'explorer au plus tôt cette piste.
Les études véto sur pirolike décrivent justement l'absence de signes systématiques associés mais d'une grande variété de manifestations qui empêchent souvent d'identifier tout ou partie des maladies du syndrome, mentionnant également le problème des faux négatifs.

 ) et au moins tu ne les laisses pas dégrader le cheval et risquer une forme chronique ou des séquelles, soit le résultat est positif et le traitement peut être parfaitement ciblé et mis en place rapidement
) et au moins tu ne les laisses pas dégrader le cheval et risquer une forme chronique ou des séquelles, soit le résultat est positif et le traitement peut être parfaitement ciblé et mis en place rapidement